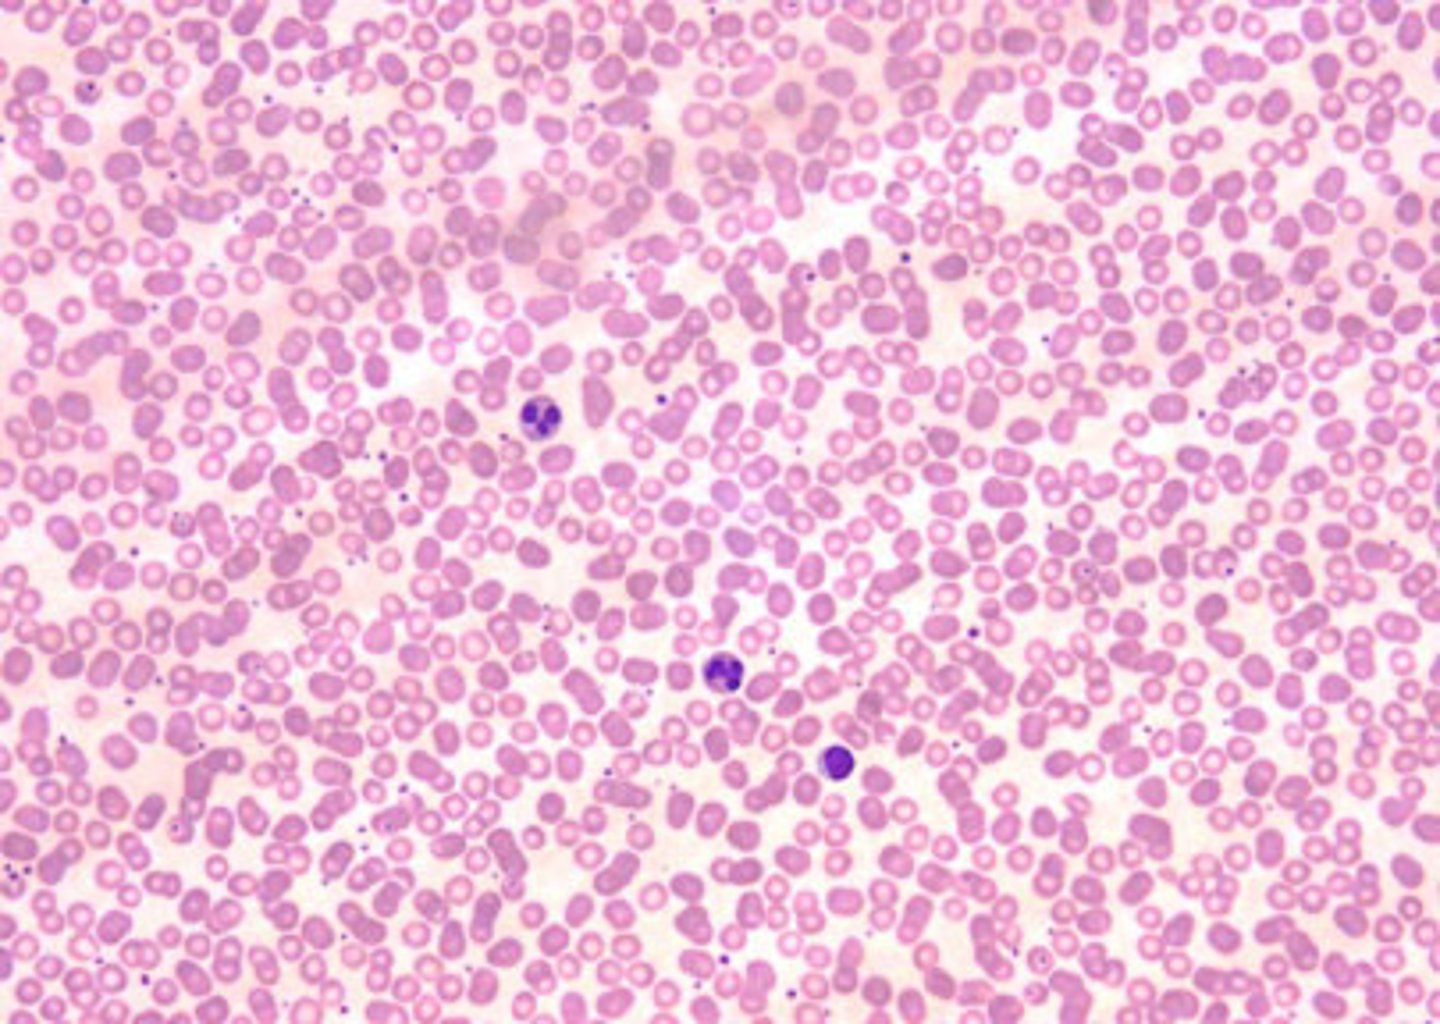

1/95
Looks like no tags are added yet.
Name | Mastery | Learn | Test | Matching | Spaced | Call with Kai |
|---|
No analytics yet
Send a link to your students to track their progress
Tissues
Groups of cells that are similar in structure and function
4 types of tissue
epithelial, connective, muscle, nervous
Tissues differ in
-cell size, shape, and arrangement, kind of intercellular substance, and location and function
Estology
study of tissues
epithelial tissue
a sheet of cells that covers a body surface or lines a body cavity
characteristics of epithelial tissue
cellularity, specialized contacts, polarity, support by connective tissue, avascular but innervated, regeneration
Cellularity
Composed almost entirely of cells with little extracellular matrix
specialized contacts
fits close together to form continuous sheets; adjacent cells are bound together by tight junctions and desmosomes
Polarity
All cells have an apical surface (free surface) exposed to the body exterior or the cavity of an interior organ, and an attached basal surface.
Most apical surfaces have what?
Microvilli: fingerlike extensions of the plasma membrane that increase the exposed surface area.
The basal surface is anchored by what?
A thin, supporting layer called the basement membrane
basement membrane
basal lamina + reticular lamina
Supported by connective tissue
all epithelial sheets rest upon and are supported by connective tissue
A vascular but innervated
No blood vessels in epithelial tissue. Must be nourished by diffusion from underlying connective tissues; are supplied by nerve fibers
Regeneration
As long as they receive adequate nutrition, epithelium can replace lost cells rapidly by cell division
Epithelial cells can be classified by
Shape and arrangement
Epithelial cells classification by shape are
Squamous, cuboidal, or columnar
Epithelial cells classification by arrangement are
Simple, stratified, and transitional
simple squamous epithelium
Description:
• Single layer of flattened cells with disc-shaped central nuclei and sparse cytoplasm
• the simplest of the epithelia
Function:
• Allows materials to pass by diffusion and filtration in sites where protection is not important
• secretes lubricating substances in serosae
Location:
• Kidney glomeruli
• air sacs of lungs
• lining of heart, blood vessels, and lymphatic vessels
• lining of ventral body cavity (serosae)

simple cuboidal epithelium
Description: Single layer of cubelike cells with large, spherical central nuclei
Function: Secretion and absorption
Location: Kidney tubules; ducts and secretory portions of small glands; ovary surface

simple colmnar epithelium
Description: single layer of tall cells with oval nuclei; layer may contain mucus-secreting unicellular glands (goblet cells)
Function: absorption; secretion of music, enzymes, and other substances; ciliated type propels mucus (or reproductive cells) by ciliary action
Location: non-ciliated type of the digestive tract, the gallbladder, and excretory ducts of some glands ciliated type line small bronchi, uterine tubes, and some regions of the uterus

pseudostratified columnar epithelium
Description: Single layer of cells of differing heights, some not reaching the free surface; nuclei seen at different levels; may contain mucus-secreting goblet cells and bear cilia.
Function: Secretes substances, particularly mucus; propulsion of mucus by ciliary action.
Location: Nonciliated type in male's sperm-carrying ducts and ducts of large glands; ciliated variety lines the trachea, most of the upper respiratory tract.

stratified squamous epithelium
Description: Thick membrane composed of several cell layers; basal cells are cuboidal or columnar and metabolically active; surface cells are flattened (squamous); in the keratinized type, the surface cells are full of keratin and dead; basal cells are active in mitosis and produce the cells of the more superficial layers
Function: Protects underlying tissues in areas subjected to abrasion
Location: Nonkeratinized type of forms the moist linings of the esophagus, mouth, and vagina; keratinized variety forms the epidermis of the skin, a dry membrane.

stratified columnar epithelium
Description: Several cell layers; basal cells usually cuboidal; superficial cells elongated and columnar.
Function: Protection; secretion.
Location: Rare in the body; small amounts in male urethra and in large ducts of some glands.

stratified cuboidal epithelium
Description: Generally two layers of cube-like cells.
Function: Protection.
Location: Largest ducts of sweat glands, mammary glands, and salivary glands.

transitional epithelium
Description: resembles both stratified squamous and stratified cuboidal; basal cells cuboidal or columnar, surface cells dome shaped or squamouslike, depending on degree of organ stretch
Function: Stretches readily, permits stored urine to distend urinary organ
Location: lines the ureters, bladder, and part of the urethra

glandular epithelium
Composed of cells that are specialized to produce and secrete substances
A gland consists of one or more cells that make and secrete a product. This product, called a secretion, is a water-based fluid that often contains protein

Glands are classified according to two sets of traits:
Site of the product released and number of cells that form the gland
Site of the product released
Endocrine and exocrine
Endocrine
secreting internally
Exocrine
secreting externally
Number of cells that form the gland
Unicellular and multicellular
Unicellular
one celled
Multicellular
many celled
ducts
Tube-like connections to the epithelial sheets
Endocrine glands
Ductless glands that empty their hormonal products directly into the blood
examples: thyroid and pituitary glands
exocrine glands
secrete chemical substances into ducts that lead either to other organs or out of the body
unicellular exocrine glands
One celled; ex. Goblet cells
multicellular exocrine glands
composed of a duct and a secretory unit, classified by structure and mode of secretion; tubular, alveolar, or tubuloalveolar
Tubular
tubes
alveolar
Sacs
tubuloalveolar
alveolar + tubular
Modes of secretion
merocrine, apocrine, holocrine
merocrine glands
release watery secretory product via exocytosis with no loss of cell membrane. This includes salivary and sweat glands
apocrine glands
lose small portions of their glandular cell bodies during secretion
This includes mammary glands
holocrine glands
accumulate their products within them until they rupture
This includes sebaceous (oil) glands
muscle tissue characteristics
Contractile, well vascularized, and responsible for most types of body movement
types of muscle tissue
skeletal, smooth, cardiac
skeletal muscle tissue
found in muscles that attach to bones and is controlled by conscious effort; cells display striations (stripes) and multiple nuclei

smooth muscle tissue
also called nonstriated (visceral) or involuntary; no cross striations; found in blood vessels and other tube-shaped organs

cardiac muscle tissue
found only in the heart, striated, involuntary

nervous tissue function
Transmit electrical signals from sensory receptors and to effectors (muscles and glands) which control their activity
nervous tissue location
brain, spinal cord, peripheral nerves
Two types of cells
neurons and neuroglia
Neurons
the basic cells of the nervous system that allow different parts of the body to communicate with each other
composed of a cell body and 2 types of processes, axons and dendrites
Axons
Carry impulses away from the cell body
Dendrites
carry impulses toward the cell body
Neurogalia
Supports and bind components of nervous tissue, are designed for phagocytosis (eating of cells), and supply nutrients to neurons by connecting them with blood vessels
connective tissue general characteristics
Most abundant tissue type
Cells are farther apart than epithelial cells; contain matrix between cells
Major cell types of connective tissue
fibroblasts, macrophages, and mast cells
Fixed cells
Cells that remain in their place
wandering cells
Move through and appear in tissues temporarily, usually in response to an injury or infection
Fibroblasts
Most common fixed cell
Large star-shaped cell
Secrete fibers into extracellular matrix

Macrophages
wandering cell, phagocytic, important in injury or infection

mast cells
-fixed cell
-release heparin
-release histamine

Heparin
Anticoagulant
anticoagulant
blood thinner
Histimine
Makes capillaries leaky
Tissue fibers
produced by fibroblasts
Tissue Fiber Types
collagen, reticular, elastic
collagenous fibers
Strong and flexible connective tissue fibers that contain the protein collagen
elastic fibers
yellow connective tissue fibers that are not particularly strong, but can be stretched and will return to their normal shape when released
reticular fibers
very fine, short collagen fibers that branch to form a supporting network
types of connective tissue
loose adipose dense cartilage bone blood and hemopoietic
loose connective tissue
(also, areolar tissue) type of connective tissue proper that shows little specialization with cells dispersed in the matrix

adipose connective tissue function
acts as a storage depot for fat; provides insulation for the body

location of adipose tissue
beneath skin, around kidneys, behind eyeballs, on surface of heart and in joint areas
dense connective tissue
binds organs; tendons, ligaments, deeper layers of skin
SLOW IN REPAIR

cartilage connective tissue
chondrocytes (cartilage cells) ; rigid tissue which stands up to both tension and compression; avascular and lacks nerve fibers

3 types of cartilage connective tissue
hyaline, elastic, fibrocartilage
hyaline cartilage
Most common type of cartilage; it is found on the ends of long bones, ribs, and nose
elastic cartilage
ear flaps and larynx; more flexible than hyaline cartilage
Fibrocartilage
tough form of cartilage, made of thick bundles of collagen fibers embedded in chondroitin sulfate ground substance found in knees, between vertebrae, and in pelvic girdle
bone connective tissue
osteocytes embedded in a solid mineral matrix

blood connective tissue
Two parts; fluid and tissue

fluid in blood
-Transports a large variety of materials
-Assists in temperature regulation
-Aids in defense against disease
-Made up of plasma
tissue in blood
Blood flow
formed of red, white blood cells, and platelets
hemopoietic connective tissue
found in the red marrow cavities; responsible for formation of blood and lymphatic system cells; in spleen, tonsils, and lymph nodes
Epithelial membrane tissue types
Epithelium and connective
Epithelial tissue types
cutaneous, serous, mucous
cutaneous membrane
The skin; composed of epidermal and dermal layers
mucous membrane
Lines all body cavities that directly open to the exterior, such as the respiratory tract, and secretes mucus
serous membrane
the moist membrane found in closed ventral body cavities
named according to their site and specific organ associations, such as pleura, pericardium, and peritoneum
pleural cavity
contains the lungs
Pericardium
Membrane surrounding the heart
peritoneum
membrane that lines the abdominal cavity